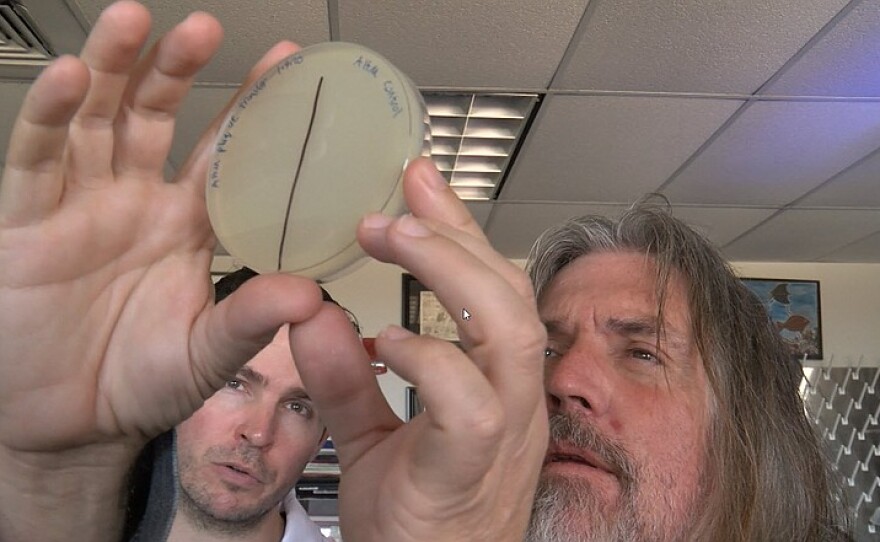

Researchers Try To ‘Sculpt The Gut’ To Improve Health And Other Local News
Speaker 1: 00:00 It's Monday, February 24th I'm Deb Welsh and you're listening to San Diego news matters from KPBS coming up. San Diego state researchers target a virus that lives in your gut as a better way to kill harmful bacteria and the media battle over a North County housing project. Voting yes on B, the better choice measure provides badly needed housing affordable for Sandra. Speaker 2: 00:23 The cost of housing keeps going up and measure B would make it worse Speaker 1: 00:27 that more coming up right after the break. Speaker 3: 00:34 [inaudible] Speaker 1: 00:37 the university of Southern California announced a policy change that will help low and middle income families. KPBS has. Donald Bloodworth has more Speaker 2: 00:45 USC president Carol L fault announced Thursday that the university will eliminate tuition for families earning $80,000 or less per year. The change also removes home equity as a factor when calculating students' financial assets. The policy change will also increase undergraduate financial aid by $30 million covering more than 4,000 students a year. Once fully implemented mural COPEC is an SDSU marketing lecturer and the founder of bottom line marketing. He told KPBS evening edition how the moovel effect applicants USCS tuition is as we know, is very high, $57,000 a year. And if you want to just go for room and board, you're pushing $80,000. Very, you know, not a lot of families can afford that, especially low and middle income families. This creates an incredible relief. COPEC says that hypothetically a 5% return on USCS $6 billion endowment could fund every freshmen's tuition for the fall 2020 semester. Donald Bloodworth KPBS news Speaker 1: 01:43 science meets art in a new exhibit called illumination at the San Diego art Institute in Balboa park. KPBS science and technology reporter Shalina Celani spoke to some of the scientists and artists about their work Speaker 2: 01:59 at the San Diego art Institute, artist and sound researcher at the Qualcomm Institute. John Burnett points to one of the speakers in his installation. Speaker 4: 02:08 It's like very algorithmic how people interact with their phones. Now. It's, it's like swiping various directions and um, saying yes and no to things, organizing data. And so I used, um, these, these algorithmic, um, processes to produce the sound in, um, in this particular piece, Speaker 5: 02:34 [inaudible] Speaker 2: 02:34 Burnett is one artist featured in this new gallery called illumination, which looks at the intersection between art, science and technology. Speaker 4: 02:41 The canvas that's available to artists is quite expansive now at the state of technology. Speaker 2: 02:49 And the broad range of techniques used here is evident throughout the gallery, which includes work from 16 local artists who paired up with scientists from seven different research institutions, San Diego. The gallery will run until May 3rd Shalina Celani key PBS news. Speaker 6: 03:08 It's been thousands of years since really large mammals, Rome, South America. But as KPBS producer, a male Eunice tells us that changed with the family zoo of the infamous drug Lord Pablo Escobar in the early 1980s Escobar's family zoo, Zune, Columbia, hows many exotic animals, including four hippos. After his death, most animals were moved to other zoos, but the hippos were set free. That population has grown to over 80 roaming wild today. UC San Diego biologist Jonathan Suran is studying the impact of the hippos on the land, Speaker 2: 03:43 right. Learned about this story. About the hippos. Uh, there was no one doing any research on it. So I said, this is too good to pass up. Speaker 6: 03:50 His research shows the hippos waste is impacting oxygen levels in lakes, which can lead to fish die offs. The local government in Colombia is trying to figure out how to manage the growing population, which is expected to reach thousands in the next few decades. I'm aluminous KPBS news. Hippocrates said, let food be your medicine and medicine. Your food researchers from San Diego state university took that ancient wisdom and they've doubled down. They're unlocking new insight into how specific foods can customize the creatures and our guts and ultimately our health. KPBS as Mya troubles, he takes us into the lab. Speaker 7: 04:29 They are everywhere. They are so important to our health. Artists have captured their likeness in different ways, trillions, trillions of them. These tripod looking creatures are called bacterial phage, more commonly known as phage. Speaker 8: 04:45 There's about 10 times as many phage in our body than there are human cells. Speaker 7: 04:51 Phage are viruses that live inside the bacteria that live inside of our gut constantly influencing our state of health or disease. Speaker 8: 05:00 Cultivate them since the moment that we're born and we have them all the way until we're dead and they're, they're just kind of part of life. Speaker 7: 05:10 Lance bowling is a molecular biologist and researcher at San Diego state university bowling as part of a team experimenting with the idea that feeding these phage common everyday foods could change the landscape of our gut microbiome in what he calls gut sculpting Speaker 8: 05:27 and by understanding the effect that these foods are having on our gut microbiota, we can kind of affect our own health in positive ways. Speaker 7: 05:36 He tested 117 consumable items, Speaker 8: 05:40 licorice, garlic, ginger, oregano, things like that that you kind of hear that have the antimicrobial properties. Speaker 7: 05:50 Dr forest rower is a microbial ecologist and biology professor at SDSU who spearheaded this study. He explains how the phage work on bacterial cells, Speaker 9: 06:01 so these viruses live inside the cells and every once in awhile they get activated, which we call induction and they jump out and they blow up the cell. The idea of this study was could we control, when do they jump out and so can we get them to kill a specific set of bacteria Speaker 7: 06:23 to test this theory? The researchers first need some phage and what better place from which to harvest phage. Then the sewage treatment plant is a great place to find phage, so that's one of the main places that we sample. And how do you harvest that? Oh, just with like a little bucket thing. It's not so hard. They then grow the phage and Petri dishes and start feeding them different foods. See, I did a top drip. The scientists measure their success by holding up the Petri dishes today. Light streaming in from the window? Speaker 10: 06:54 No, and that's where the bacteria are being killed by the phages. Speaker 7: 06:59 This method, they can see a clearing that's cool, indicating where the phage have killed a specific species of bacteria, Speaker 10: 07:07 a really clear area. And then there's a second clear area. Speaker 7: 07:10 The cloudy areas are where the bacteria are still growing abundantly. Speaker 9: 07:14 Well, if you're trying to change the, the relative numbers of this bacteria versus that bacteria, could you just eat this stuff and do that? Speaker 7: 07:22 What is most remarkable is the ability to kill certain bacteria without affecting other beneficial bacteria. Researchers believe this could mean the potential for more gentle options without annihilating the entire microbiome as some antibiotics do. Speaker 9: 07:37 So we want things that will kill this bacteria, but not that bacteria, but even better. We'd like to be able to, uh, adjust some of these different types of bacteria. So you may not want to kill all of a particular bacteria off, but you want to kill most of them off. So these things would hopefully be able to do that. Speaker 7: 07:55 They found honey, Stevia, neem, and artificial sweeteners to have the most impact on the phage. They also tested toothpaste. Speaker 8: 08:04 We think you just kind of brush your teeth and spit it out, but maybe some of that residual, uh, antimicrobials that are in the toothpaste are affecting our gut microbiota in ways that we're unaware of. Speaker 7: 08:16 His gut was right. Toothpaste had a strong effect, but before you consume more than your fill of these powerful phage inducing compounds, there are so much more to learn about these creatures that outnumber our own human cells. Speaker 8: 08:30 A lot of the foods are surprisingly powerful antimicrobials and we just don't even realize it. Speaker 7: 08:37 Maya treble C K PBS news Speaker 1: 08:40 measure B is the most expensive battle in San Diego County. Over an initiative on the March ballot with more than $11 million in the fight. KPBS reporter Eric Anderson says the measure asks County voters to support the construction of a major North County housing development along the interstate 15 Speaker 11: 08:59 a developer for the Newland Sierra housing project in the North County is spending millions to get voter approval to build 2100 homes, schools, retail space, hiking and bike trails. Newland Sierra once voters to back San Diego County supervisors who approved the project two years ago, opponents disagreed and pushed for a County wide vote and that's why measure B is on the ballot, but Newland Sierra argues the supervisors were right to okay the project North of Escondido Speaker 12: 09:27 voting yes on measure B creates a community that is a smart plant community. We're located less than a mile from infrastructure in the major cities. I'm in North San Diego County. That includes Vista, Escondido San Marcos. Speaker 11: 09:40 Yes. On measure B campaign spokesman Kenneth Morris says the project will preserve 1200 acres of open space. He says there's already plenty of development nearby. So building here doesn't change the character of the land. Speaker 12: 09:52 We're surrounded by existing development and existing homes. Within a three mile radius of the project, there's nearly 33,000 existing homes and when you go to a five mile radius of the project, there's about 90,000 homes that are already built. An existing Speaker 11: 10:05 and Newland Sierra is making sure voters see their message saying this land is going to be developed one way or the other. There are mailers, digital ads, and television spots. Speaker 1: 10:16 Voting yes on B, the better choice measure provides badly needed housing affordable for San Diego counties, working family. Speaker 11: 10:23 Those ads cost money. San Diego County campaign finance disclosure documents show that Newland Sierra L L C is funding two committees supporting measure B. Newland put five point $6 million in one and about 2.4 million in another since the beginning of last year. The more than $8 million is fueling the ad campaigns. Speaker 1: 10:46 Voting no on B leaves. Unmaintained land vulnerable to wildfires and no new money for fire prevention. Speaker 11: 10:53 But the fight is not one sided resident's opposed to the plan. Have a rich ally campaign documents show that golden door properties owners have an upscale spa near the proposed community, raised three point $3 million to convince voters the project is wrong for the region. Measure B opponents are also spending on television and digital ads. Speaker 13: 11:14 The cost of housing keeps going up and measure B would make it worse. Measure B, the Newland Sierra project is a luxury development. Speaker 11: 11:24 DOR properties is putting most of the bill to fight Newland Sierra, but one anti sprawl group has spent just under $3,000 on yard signs. The no one B camp says there are other locals in the fight as well. Speaker 14: 11:36 This is a community against a developer, right? Speaker 11: 11:39 Cliff Williams is a Newland Sierra opponent. Speaker 14: 11:42 This is a community also that participated in a process where they were told that this land was not going to be developed in a significant way and the County broke promise and I in allowed this development to go forward and so because they broke their promise, the people are taking back their right to put this on. The ballot. Speaker 11: 12:04 Mailers and television advertising are stock vehicles for driving public opinion, but the chair of the San Diego state university marketing department says there's a shift underway. Heather ho ne says money spent on digital advertising is eclipsing the traditional ads as a way to reach voters. Speaker 6: 12:20 I think that trend will continue and to the degree that we get more and more granular information, there'll be a lot of inefficiencies. What's kind of this broadcast model of communication? I don't think it's ever going to go away entirely because it is a mechanism to create basic awareness and I think we'll still continue to see ad dollar spent there. Speaker 11: 12:42 Even more money could be sunk into the battle for measure B because there's more time between now and election day to make contributions a yes vote on measure B allows the development to move ahead. A no vote rejects the project. Eric Anderson KPBS news, Speaker 6: 13:05 thanks for listening to San Diego news batters. Do us a favor, and if you appreciate the podcast rate or review us on Apple podcasts or wherever you listen to podcasts. Speaker 5: 13:17 Thank you.